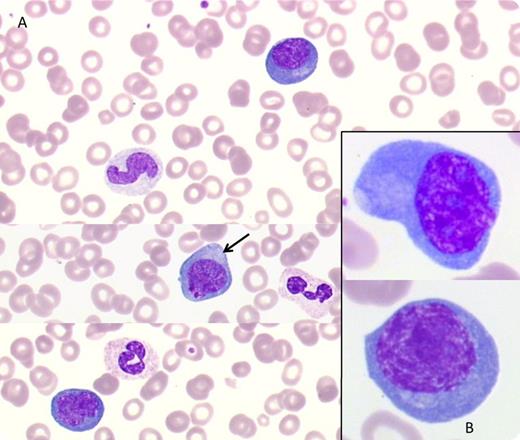

A 60-year-old woman with an 8-year history of HIV infection was admitted for cough and fever. A visceral and cutaneous Kaposi sarcoma diagnosed 2 years previously was in partial response (PR) after doxorubicin. Chest and abdomen computed tomography scan revealed diffuse adenopathy and splenomegaly, felt to be inconsistent with the Kaposi sarcoma PR. Blood count showed anemia at 102 g/L, thrombopenia (90 × 109/L), leukocytosis (13.73 × 109/L), and lymphocytosis (4.26 × 109/L) with 0.394 × 109/L CD4+ T cells. An HIV viral load test was negative.
Peripheral blood smears showed large activated cells with nuclei containing 1 to 2 prominent nucleoli and abundant basophilic cytoplasm (panel A, ×40; panel B, ×100, May-Grünwald-Giemsa stain). Flow cytometry disclosed 12% of nucleated cells with high side scatter, CD19+, CD38+, surface λ light-chain restriction, lacking CD20, CD22, and CD138. This clonal B-cell proliferation suggested a diagnosis of multicentric Castleman disease in leukemic phase confirmed by the evidence of human herpesvirus 8/Kaposi sarcoma associated herpes virus (HHV8/KSHV) viral load test positive, demonstration of cytoplasmic hofs (panel A, arrow), and pathology. Treatment with cyclophosphamide, vincristine, and prednisone and with rituximab combined with low-dose cyclophosphamide, doxorubicin, vincristine, and prednisone improved the patient’s condition. Rarely occurring HHV8-positive plasmablastic lymphoma involves lymph nodes, spleen, and other viscera but seldom manifests as leukemia. This case stresses the importance of performing immunophenotyping in immunosuppressed patients where such cells could be mistaken for activated T lymphocytes.
A 60-year-old woman with an 8-year history of HIV infection was admitted for cough and fever. A visceral and cutaneous Kaposi sarcoma diagnosed 2 years previously was in partial response (PR) after doxorubicin. Chest and abdomen computed tomography scan revealed diffuse adenopathy and splenomegaly, felt to be inconsistent with the Kaposi sarcoma PR. Blood count showed anemia at 102 g/L, thrombopenia (90 × 109/L), leukocytosis (13.73 × 109/L), and lymphocytosis (4.26 × 109/L) with 0.394 × 109/L CD4+ T cells. An HIV viral load test was negative.
Peripheral blood smears showed large activated cells with nuclei containing 1 to 2 prominent nucleoli and abundant basophilic cytoplasm (panel A, ×40; panel B, ×100, May-Grünwald-Giemsa stain). Flow cytometry disclosed 12% of nucleated cells with high side scatter, CD19+, CD38+, surface λ light-chain restriction, lacking CD20, CD22, and CD138. This clonal B-cell proliferation suggested a diagnosis of multicentric Castleman disease in leukemic phase confirmed by the evidence of human herpesvirus 8/Kaposi sarcoma associated herpes virus (HHV8/KSHV) viral load test positive, demonstration of cytoplasmic hofs (panel A, arrow), and pathology. Treatment with cyclophosphamide, vincristine, and prednisone and with rituximab combined with low-dose cyclophosphamide, doxorubicin, vincristine, and prednisone improved the patient’s condition. Rarely occurring HHV8-positive plasmablastic lymphoma involves lymph nodes, spleen, and other viscera but seldom manifests as leukemia. This case stresses the importance of performing immunophenotyping in immunosuppressed patients where such cells could be mistaken for activated T lymphocytes.
For additional images, visit the ASH IMAGE BANK, a reference and teaching tool that is continually updated with new atlas and case study images. For more information visit http://imagebank.hematology.org.
This feature is available to Subscribers Only
Sign In or Create an Account Close Modal